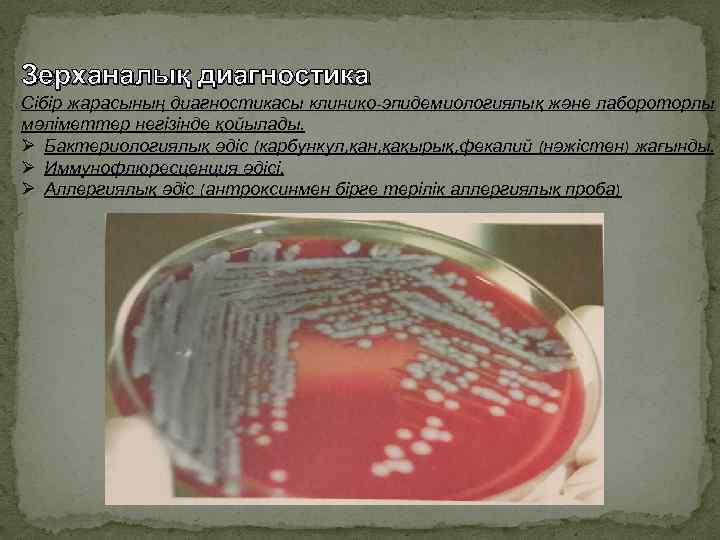
Зерханалық диагностика Сібір жарасының диагностикасы клинико-эпидемиологиялық және лабороторлы мәліметтер негізінде қойылады. Ø Бактериологиялық әдіс

KURS.pptx
- Количество слайдов: 19

«Астана медицина университеті» АҚ Иммунология курсымен жұқпалы аурулар және эпидемиология кафедрасы Курстық жұмыс Тақырыбы: Қазақстан Республикасында сібір жарасы ауруының таралу көрсеткіштері Жетекші: Ильясов Б. Б Орындаған: Исембиев Е. А Тобы: 507 ОЗ Астана 2017 ж

Жоспары І. Кіріспе ІІ. Негізгі бөлім 1) Этиологиясы. 2 ) Қоздырғыш көзі 3) Берілу механизмдері, факторлары мен жолдары. 4) Факторлары: 5) Статистикалық мәліметтер 6) Эпидемияға қарсы шаралар. ІІІ. Қорытынды ІV. Пайдаланылған әдебиттер

І. Кіріспе Түйнеме Адамдар мен жануарлардың жедел жұғатын жұқпалы індеті. Сібір жарасы-жіті жұқпалы ауру. Көбінесе тері жамылғысында көрініс береді, өкпе мен ішектерде сепсис түрінде өтуі-сирек кездеседі. Аурушаңдық Азия, Африка, Оңтүстік Америка елдерінде көп тараған. Оның ошақтары Ресей, Татарстан, Қазақстан және тағы басқа да елдерде бар. Қазақстан Республикасы аумағында соңғы 60 жыл ішінде 1700 -ден астам сібір жарасы бойынша стационарлы-қолайсыз пункттер тіркелген.

Адамдарға жұғу

Қоздырғышы- Bacillus anthracis ірі, грамм оң, капсула және спора түзетін, факультативті аэробты таяқша. Табиғатта екі түрде-вегетативті және спора түзген кездеседі. Спора түрінде тек абиотикалық ортада ғана, ал вегетативті түрде тек жануарлар және адам организмінде болады. спора түріндегі микробтар өте төзімді. Олар суда бірнеше жыл, топырақта бірнеше оңдаған жылдар бойыны сақтала алады. Споралар қолайлы қоректік, температуралық ылғалдылық жағдай туғанда көбейіп, қайта споралық күге ауыса алады. Сөйтіп абиотикалық ортада ошақтылықты сақтап тұрады. Споралар 120 -140 С құрғақ ыстықта 1 -3 сағатта жойылады, автоклавта 180 С -24 минутта, белсендірілген ерітіндісі, 6% сутегінің асқан тотығы спорациттік әсер етеді. Ол тұздалған теріде де тіршілік ете береді. Ауру қоздырғышы сыртқы ортада сапрофит ретінде өмір сүріп, шаң-тозаң, ағынды су, қан сорғыш кенелер арқылы бір жерден екінші жерге ауысып жанадан індет ошағын құрайды.

Инфекция көзі • Жиі ірі және ұсақ малдар, жылқы (60 -85%) • Сирек шошқа, түйе, есе, жабайы жануарлар. Жұқпа көзі және қоздырғыштың резервуары шөп коректі жануарлар (сиыр, жылқы, түйе, ешкі, қой, шошқа т. с. с) Жануарларда ауру негізінен ішектік және нәжісімен бөлінеді. Ауру мал заладылығын жазылғанша немесе өлгенше (80% дейін) сақтайды. Өлген малдың денесі 7 күнге дейін залалды, Ауру малдан алынған өнім (жүні , терісі, мүйізі т. б) көп жылдарға дейін қауіптілігін жоймайды. Ауру адамның эпидемиологиялық қауіптілігін аурудың клиникалық формаларына байланысты. Терілік формасы қауіпсіз саналады.

Берілу механизмі: • Жанасу-тікелей жанасу арқылы жұғады; малға қарағанда, сойғанда, терісін сылағанда, етін өндегенде, жүн, тері жинап, өндегенде • Трансмиссивті-маса, қансорғыш шыбындардың шағуы арқылы жұғады. • Аспирациялы-ауа-шаң арқылы жүн, тері жинайтындар арасында кәсіптік ауру түрінде кездеседі. Берілу жолдары: • Алиментарлы • Ауа-тамшы, ауа-шаң Берілу факторлары • Біріншілік берілу факторлары-зәр, нәжіс, қан, ет, тері, жүн; • Екіншілік-саймандар, шөп, жем, т. с. с 5% жағдайда қоздырғыш адам организіміне аэрозольді немесе тағам жолымен енеді. Ауа-шаң (аэрогенді) жолы ауыл шаруашылық қызметкерлері арасында, техникалық қызметкерлер жүзеге асуы мүмкін. Инкубациялық кезең: Инкубация кезеңінің ұзақтылығы терілік формада бірнеше сағаттан 14 күнге дейін, сепсистік формада 6 -8 күн.

Факторлары Жастық- барлық топтарында кездеседі, көбіне ересек адамдар ауырады Кәсіптік- мал қожалығында жұмыс жасайтын адамдар ауырады. Мерзімдікжаз-күз Жыныстық-ер кісілерде көп кездеседі. Қалалық-ауылдықкөбіне ауыл тұрғындары ауруға шалдығады Климаттық-географиялықсібір жарасы мал шаруашылығы дамыған елдерде жиі кездеседі.

Аурушаңдықтың клиникалық белгілері Қоздырғыш енген тері жамылғысында 2 -3 күн өткен соң қызылтым немесе көкшіл түсті дақ пайда болады. Сол жер қышып, теріні сәл күйдіргендей болып басталып, үдей түседі. Бөртпе 12 -24 сағат өткеннен кейін диаметрі 2 -3 мм, ішінде ашық түсті сұйықтығы бар күлдіреген бөртпеге айналады, уақыт өте келе оның ішіндегі сұйықтық қою түске боялып, қан араласады. Бөртпе қышып шыдатпаған соң, ауруға шалдыққан адам оны қасып, бетін жаралап тастайды. Іріңді бөртпенің орнына беті ашылған өлі етті қабыршақ пайда болады. Дәл осы қабыршақ сібір жарасының негізгі белгісі, дерттің атауы да осы қара даққа ( «anthrax» - «углевик» ) байланысты шыққан. Қабыршақ қатты, тығыз, күйдірілген сияқты болады. Оның айналасын қызыл түсті жиек қоршайды.

7 Қазақстандағы сібір жарасы бойынша мезгілділік динамикасы 2006 -2016 6 5 4 3 2 1 ст се нт яб рь ок тя бр ь но яб рь де ка бр ь гу ав ль ию нь ию ма й ел ь ап р т ма р ал ь вр фе ян ва рь 0

Тіркелінген жылдар 20 10 20 0 1997 -2000 11 2001 -2004 8 2005 -2009 Қазақстан Республикасында 1997 -2009 ж жаралығы кезеңінде ауыл шаруашылық жануарлары арасында сібір жарасы тіркелуі. (Л. Ю. Лухнова мәліметтері бойынша)

Сібір жарасының сырқаттанушылығы Кәсіптікауылшаруашылық 10% Кәсіптік-индустриальді 20% 70% Тұрмыстық жағдай
Зерханалық диагностика Сібір жарасының диагностикасы клинико-эпидемиологиялық және лабороторлы мәліметтер негізінде қойылады. Ø Бактериологиялық әдіс (карбункул, қан, қақырық, фекалий (нәжістен) жағынды. Ø Иммунофлюресценция әдісі. Ø Аллергиялық әдіс (антроксинмен бірге терілік аллергиялық проба)

Аурудың терілік түрі: Емі уақтылы басталмаса , өлім – жітім 2%. Емі мүлдем жасалмаса, өлім-жітім 20%. Aурудың өкпелік түрі. Өлім-жітім өте жоғары. Уақтылы ем қабылданса да, өлім-жітім 90 -95% Болжамы Аурудың асқазанішек түрі: Өлімжітім 50% Аурудың септикалық түрі: Өлім-жітім өте жоғары

Індетке қарсы шаралар 1. Ошақтағы жасалатын шаралар. ü Науқас адам міндетті түрде инфекциялық аурулар ауруханасында емделеді. ü Ошақта ветеринарлық карантин -15 күн ü № 58 үлгідегі СЭҚБ шұғыл хабарлама беру, ошақта эпидемиологиялық тексеру жүргізу. ü Қатынаста болғандарды , ауру малды өндегендерді 8 күн медициналық бақылау. ü Енжар иммунизация ретінде 20 -25 мл иммундыглобулин егу. ü Шұғыл алдын алу ретінде 5 күн антибиотиктер беру (тетрациклин, доксицклин, ципрофлоксин) ü Бактериялық аллергиялық сынамалар жасау. ü Ауру малдың мәйіті және мал өнімдері өрттеу немесе арнайы Беккери шұңқырына көму арқылы жойылады.

2. Ветеринарлық-санитарлық шаралар Күйдіргі бойынша қауіпті пункттер 4 жыл бақылауда болады, арнайы журналға тіркеледі. Ошақтың шекрасына «күйдіргі» белгісі қойылады. Ошақтан малдарды шығаруға және сырттан жаңа мал кіргізуге тыйым салынады. Мал базарлары, тері, жүн жинайтын, сақтайтын жерлер қатаң қадағалауға алынады. Малдарға сібір жарасына қарсы вакцина егіледі. Ауру және күдікті малды мал дәрігері тексеруі қажет, ветеринарлық рұқсатсыз союға тыйым салынады. Етті зертзаналық тексерусіз, ветеринарлық куәліксіз сатуға тыйым салынады. Өлген малдың терісін сылуға болмайды v Сақтандыратын киім кию: комбинезон, капюшон, резеңкелі алжапқыш, қолғап, бетперде.

Эпидемиологиялық бақылау әртүрлі әлеуметтік жас топтарындағы аурушаңдылық пен өлімді бақылап қана коймай, олардың инфекция таралуына ықпал ететін факторларын бақылайды. Эпидемиологиялық талдау мен жүргізілетін шаралар тиімділігін бағалау, нақты аумақта сібір эпидемиялық процесінің инсивтілігін болжау маңызды орын алады. Ø Санитарлық-эпидемиологиялық қадағалау. Ø Санитарлық-ветеринарлық қадағалау. Ø Қауіп-қатер топты анықтап, бақылауға алу. Ø Жағдай уақытын анықтау. Ø Қауіпті пункттерді, мал қожалықтарын анықтап, тіркеуге алу. Ø Белсенді түрде бақылау жүргізу. Ø Вакцина егілуін қадағалау. Ø Санитарлық ағарту жұмыстарын жүргізу.

Қорытынды Курстық жұмыста сібір жарасының сырқаттану динамикасын қарастырдық. Қазақстан Республикасындағы сібір жарасы бойынша эпизоотиялық жағдай талдауы анықталынған сау емес елді мекендер саны үнемі азаю тұрғысында өзгеріп келетінін көрсетті. Егер 2000 және 2001 ж. жалпы саны -6 елді-мекен анықталса, 2003, 2004 және 2005 жж. тиісінше-3, 2 және 1 сау емес елді мекен анықталған. Соңғы жылдары бұл ауру республикада аумағында тіркелмеген. Аталған аурудың осыған ұқсас тұрғыда азайып өзгеру динамикасы байқалуда.

Қолданылған әдебиеттер 1. » Инфекционные болезнь и эпидемиология» В. И. Покровский, 2007 2. » Сибирская язва» Лобанова Т. П. Кихтенко Н. В 3. » Эпидемиология» уч. пособие для вузов/В. В. Власов-2 е. изд-Медиа, 2005 -464 б 4. » Эпидемиология» том Амирев. С. А. Алматы 2002 5. Зубик Т. М. Дифферинциальная диагностика инфекционных болезней-Л. . 1991 6. Руководства по инфекционным болезням/Ю. В Лобинредакциясымен 7. Әміров С. Ә , Момынов Т. Ә, Чернасский Б. Л, Оспанов К. С , Жұқпалы аурулардың алгоритмдері 1 т. Алматы 2009
KURS.pptx